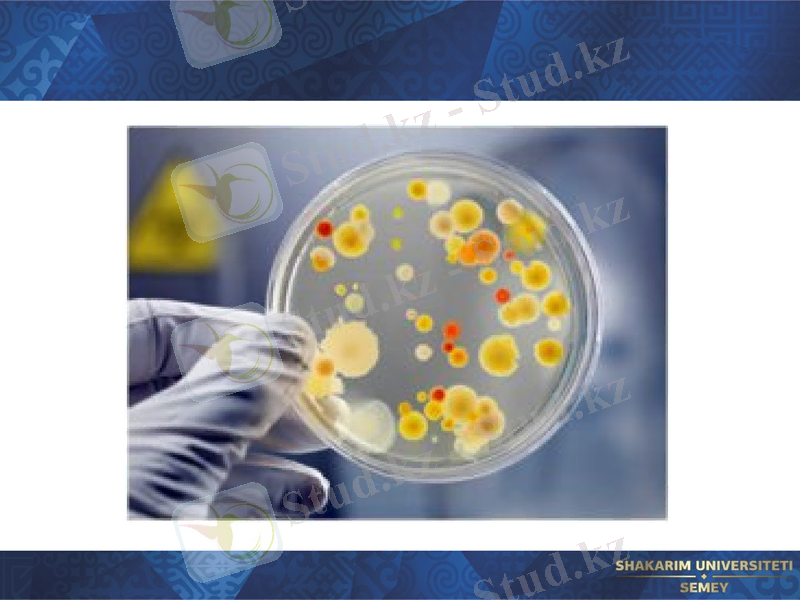
Slide 14

Вирусологиялық зерттеу әдістері: алынатын материалдар, торша өсіндісіндегі патоморфологиялық өзгерістер және нейтрализация реакциялары



Вирусологиялық балау әдістері

Жоспар:
I. Кіріспе
II. Негізгі бөлім
2. 1. Вирусологиялық зерттеу әдісі
2. 2. Алынатын патологиялық материал
2. 3. Торша өсіндісіндегі патоморфологиялық өзгерістері
2. 4. Нейтралдау реакциясы
III. Пайдаланылған әдебиеттер

Вирустық инфекциялардың лабораторлық диагностикасының принциптері зерттеу әдістері
Вирусологиялық әдіс - патологиялық материалдағы вирусты анықтау.
Серологиялық әдіс - аурудың қан сарысуынан вирусқа қарсы антиденелерді анықтау.
Вирустық инфекциялардың экспресс-диагностикасы: жылдамдатылған серологиялық және вирусоскопиялық әдіс.

Әдістер
Зерттеу мақсаты
Вирусологиялық әдіс
Вирусты биологиялық сезімтал обьектілерден НР, РТГА, РТГ, ИФА, РИФ, РИА, РСК және басқа да реакциялар арқылы анықтайды.
Серодиагностика
Вирустарға қарсы қан сарысуындағы антиденелер титрін НР, РТГА, РИФ, ИФА, РИА, РСК реакциялары арқылы анықтайды.
Экспресс-диагностика
Клиникалық материалда вирус бөлшектерін немесе вирус спецификалық антигендерді РИФ, ИФА, РИА, ЭМ, ИЭМ және басқа да реакциялар арқылы анықтайды.

Вирусологиялық зерттеу әдісі 2 кезеңнен тұрады:
А) клиникалық материалдан вирустарды бөліп шығару.
Б) бөлінген вирустардың түрлерін анықтау немесе салыстыру.

Алынатын патологиялық материал
Вирусты анықтау үшін алынатын зерттеу материалы әртүрлі болады, ол инфекциялық процестің динамикасына және вирустың тропизміне байланысты. Мысалы: тұмау болса жұтқыншақтан бөлінетін шырыш, везикуладан қырып алынған материал; құтыру ауруында зақымдалған малдың сілекейі және өлгендердің ми тіндері, сілекейдегі бөлінділері зерттеледі.

Вирусты анықтау мақсатында патологиялық материалмен сезімтал лабораториялық жануарларды, тауық эмбриондарын және торша өсіндісіне жұқтырады: Мысалы: тұмау инфекциясында вирус бар материалды торша өсіндісіне егіп немесе күзендер мен тышқандардың мұрын қуысы арқылы жұқтыруға болады. Вирусологиялық зерттеуде біркелкі жануарларды пайдаланған дұрыс. Өйткені олардың генотиптік және фенотиптік қасиеттері ұқсас инфекцияға өте сезімтал.


Патологиялық материалда вирус болған кезде жануарларда инфекциялық аурулардың клиникалық белгілері мен өзгерістері пайда болады. Мысалы: Құтыру вирусымен зақымдалған тышқандардың аяқ-қолдары жансызданады да өледі. Тауық эмбрионының қабықтарын, аллантоис, амнион қуыстарында вирустың көбейгенінен эмбрион тұқымы зақымданып одан әрі өсуі тоқтатылады.

Торша өсіндісіндегі патоморфологиялық өзгерістері мынадай: вирустар репродукциясы ядроның немесе цитоплазманың құрылымдарын зақымдап өзгертеді немесе торшаны жансыздандырады. Сондықтан, микроскоп арқылы вирус зақымданған торшада мына өзгерістерді анықтауға болады:

Торша ішіне тән патоморфологиялық өзгерістер. Мысалға, құтыру ауруында нейрондардың цитоплазмасында Бабеш-Негри денешіктері анықталады

2. зақымдалған торша ішіндегі вирустар гемадсорбция - Ргадс реакциясы арқылы анықталады. Вирустық компоненттер, оның ішінде эритроциттерді агглютинациялайтын гемагглютининдер зақымдалған торшаның мембранасына бекінеді. Сондықтан вирустармен зақымдалған торшалық суспензияға қосылған эритроциттердің 1% қоспасы торша мембранасына адсорбцияланады.

3. бляшкалар әдісі, бұл вирустың цитопатиялық әсерін байқау модификациясы. Вирус әсерімен байланысты бір қабатты торша өсіндісінің дөңгелек сияқты бүліншегін бляшкалар деп атайды. Бұл әдісте бір қабатты торшаларды вирустардың аз концентрациясымен зақымдайды және торша бетіндегі вирустық бөлшектерін агармен ұстатады (фиксация), ал агарға витальді бояғыш - нейтральды қызыл қосылған.

Бұл жағдайда вирустардың цитопатиялық әсері бір жерге топталған, ал өлген торшалар бояуды ұстау қасиетін жоғалтып түссізденеді. Соның әсерінен бір қабатты торшалардың мөлдір емес қызғылт фонында айқын бляшкалар пайда болады. Олар мөлдір, түссіз дөңгелек таңба сияқты болады.

Нейтралдау реакциясы
1. нейтралдау реакциясында түрлі-түсті сынама қолданылады. Түрлі-түсті сынаманы өткізу үшін белгілі компонент - торша өсіндісіне (Игла немесе 199 қоректік орта) және вирусты материал түріне спецификалық сарысу қолданылады. Вирустың бөліктері антиденелермен нейтралданса бұл реакция нәтижелі деп саналады. Тіндік торшалар вирустармен зақымданбай өмір сүруге бейім қалпында қалса, олардың зат алмасуынан қышқыл заттар пайда болады. Сондықтан қоректік ортада рН төмендейді және оның қызыл түсі сарыға ауысады:

2. цитопатиялық әсерге байланысты нейтралдау реакциясы. Реакция компоненттері: бір қабатты торша өсіндісі, вирус құрайтын материал және белгілі түрге спецификалық сарысу. Вирустық антигендер антиденелермен нейтрализациялағанда тіндік торшалары бұзылмай қалады. Сондықтан, микроскопта цитопатиялық өзгеріс жоқ, мұндай реакция нәтижелі деп саналады.


- Іс жүргізу
- Автоматтандыру, Техника
- Алғашқы әскери дайындық
- Астрономия
- Ауыл шаруашылығы
- Банк ісі
- Бизнесті бағалау
- Биология
- Бухгалтерлік іс
- Валеология
- Ветеринария
- География
- Геология, Геофизика, Геодезия
- Дін
- Ет, сүт, шарап өнімдері
- Жалпы тарих
- Жер кадастрі, Жылжымайтын мүлік
- Журналистика
- Информатика
- Кеден ісі
- Маркетинг
- Математика, Геометрия
- Медицина
- Мемлекеттік басқару
- Менеджмент
- Мұнай, Газ
- Мұрағат ісі
- Мәдениеттану
- ОБЖ (Основы безопасности жизнедеятельности)
- Педагогика
- Полиграфия
- Психология
- Салық
- Саясаттану
- Сақтандыру
- Сертификаттау, стандарттау
- Социология, Демография
- Спорт
- Статистика
- Тілтану, Филология
- Тарихи тұлғалар
- Тау-кен ісі
- Транспорт
- Туризм
- Физика
- Философия
- Халықаралық қатынастар
- Химия
- Экология, Қоршаған ортаны қорғау
- Экономика
- Экономикалық география
- Электротехника
- Қазақстан тарихы
- Қаржы
- Құрылыс
- Құқық, Криминалистика
- Әдебиет
- Өнер, музыка
- Өнеркәсіп, Өндіріс
Қазақ тілінде жазылған рефераттар, курстық жұмыстар, дипломдық жұмыстар бойынша біздің қор #1 болып табылады.



Ақпарат
Қосымша
Email: info@stud.kz